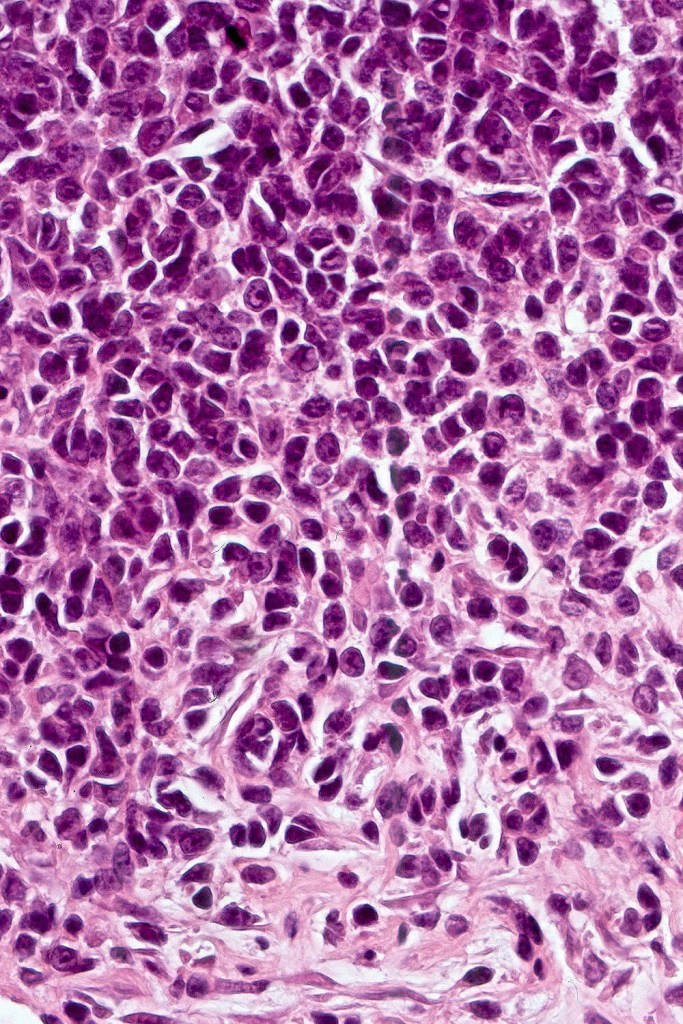
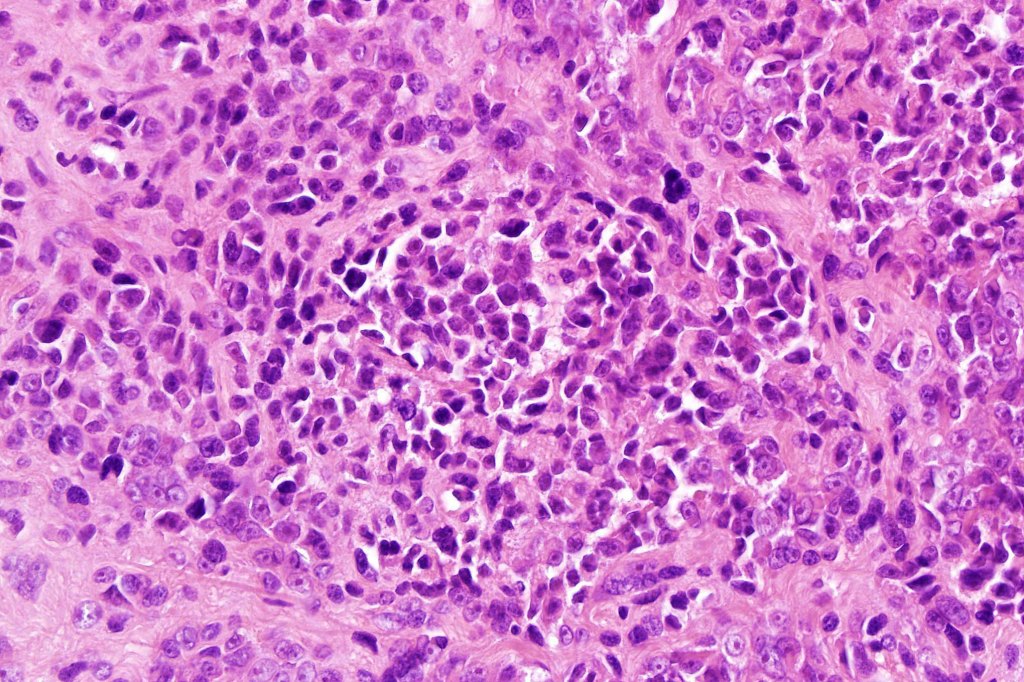

A rare variant of nevoid melanoma wherein the tumor cells have scant cytoplasm, and basophilic, hyperchromic nuclei mimicking type B nevus cells. Typically, the tumor cells are positive for S100, Mart-1 & HMB45. It is of no prognostic importance. It is one of the more often encountered melanoma variants in giant congenital nevi & can be mistaken for a congential nevus if the lesion is dismissed as benign at scanning magnification. In the absence of clinical history in metastatic lesions, the differential diagnoses of lymphoblastic leukemina/lymphoma, neuroendocrine carcinoma, small cell carcinoma, neuroblastoma, malignant perihperal nerve sheath tumor & Ewing’s sarcoma can be excluded with appropriate immunohistochemistry. Exceptionally small cell melanoma may express neuroendocrine markers

Leave a comment